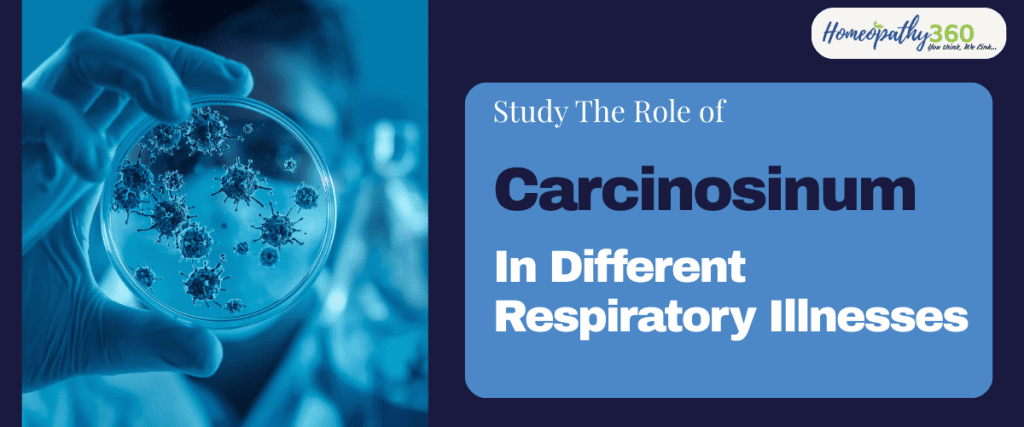

Abstract
Respiratory illnesses such as bronchial asthma, allergic rhinitis, chronic bronchitis, and chronic obstructive pulmonary disease (COPD) are common chronic conditions that significantly affect the quality of life. Homoeopathy offers a holistic and individualized approach to the management of these conditions by addressing the constitutional makeup and miasmatic background of the patient. Carcinosinum is a deep-acting constitutional homoeopathic remedy frequently indicated in chronic diseases, particularly in individuals with hypersensitivity, recurrent infections, and a strong family history of chronic ailments. This review study aims to evaluate the role of Carcinosinum in different respiratory illnesses through an analysis of classical homoeopathic literature, materia medica, repertorial references, and published clinical experiences. The study highlights the therapeutic relevance of Carcinosinum in improving respiratory health and its importance as a constitutional remedy in chronic respiratory disorders.
Keywords
Carcinosinum, Respiratory illnesses, Bronchial asthma, Allergic rhinitis, Homoeopathy, Constitutional remedy.
Introduction
Respiratory diseases constitute a major global health burden and include a wide range of acute and chronic disorders affecting the upper and lower respiratory tract. Chronic respiratory illnesses such as bronchial asthma, allergic rhinitis, chronic bronchitis, and COPD are characterized by recurrent episodes, hypersensitivity reactions, and long
term morbidity. Conventional treatment modalities mainly aim at symptomatic relief and disease control; however, they often fail to address the underlying susceptibility and constitutional tendencies of the individual.
Homoeopathy, founded by Dr. Samuel Hahnemann, is based on the principle of Similia Similibus Curentur—let like be cured by like. It emphasizes the totality of symptoms, constitution, and miasmatic background of the patient. In chronic diseases, deep-acting constitutional remedies play a vital role in modifying disease progression and improving overall health.
Carcinosinum is a nosode prepared from cancerous tissues and is considered a powerful constitutional remedy. It has a marked affinity for the respiratory system and is frequently indicated in chronic respiratory illnesses associated with hypersensitivity, recurrent infections, and a strong family history of malignancy, tuberculosis, diabetes, or allergic disorders.
AIM:
Study The Role Of Carcinosinum In Different Respiratory Illnesses
OBJECTIVE :
1. Prescribe carcinosin in patient of different respiratory illnesses according to symptoms similarity.
Materials and Methods
This study is a literature-based review. Data were collected from classical homoeopathic texts, materia medica, repertories, journals, and published articles related to Carcinosinum and respiratory diseases. Standard homoeopathic references such as Allen’s Keynotes, Boericke’s Materia Medica, Clarke’s Dictionary, and Kent’s Repertory were consulted. Relevant information was compiled, analyzed, and systematically presented.
Concept of Carcinosinum
Carcinosinum is a nosode derived from cancerous tissue and was introduced into homoeopathic practice by Burnett. It is considered a deep-acting remedy with a strong influence on the nervous, glandular, and respiratory systems. Carcinosinum is often indicated in individuals with a history of prolonged grief, stress, suppression of emotions, and long-standing chronic diseases.
Constitutional Features of Carcinosinum
Patients requiring Carcinosinum often exhibit marked sensitivity to environmental stimuli, food, and emotions. They are perfectionistic, conscientious, and have a strong sense of responsibility. There is frequently a family history of cancer, tuberculosis, diabetes, or chronic allergic disorders. These individuals are prone to recurrent respiratory infections and allergic manifestations.
Role of Carcinosinum in Respiratory Illnesses
Bronchial Asthma
Carcinosinum is indicated in chronic bronchial asthma with recurrent attacks, especially in patients with a strong allergic background. Symptoms may worsen at night, with sensitivity to dust, smoke, and weather changes. The remedy helps in reducing the frequency and intensity of asthmatic attacks when prescribed constitutionally.
Allergic Rhinitis
In allergic rhinitis, Carcinosinum is useful in individuals with persistent sneezing, nasal obstruction, watery discharge, and marked hypersensitivity to allergens. It is particularly effective in cases with a family history of allergies or asthma and in patients who have undergone prolonged conventional treatment with suppression.
Chronic Bronchitis
Carcinosinum plays a role in chronic bronchitis characterized by recurrent infections, persistent cough, and excessive expectoration. It is beneficial in patients with long standing illness, lowered vitality, and a tendency toward repeated respiratory complaints.
Chronic Obstructive Pulmonary Disease (COPD)
Although structural changes in COPD are often irreversible, Carcinosinum may help in improving general health, reducing exacerbations, and enhancing the quality of life when used as a constitutional remedy alongside indicated medicines.
Repertorial References
Repertorial analysis shows the presence of Carcinosinum under rubrics related to asthma, cough, dyspnoea, allergic tendencies, and hypersensitivity. Kent’s Repertory and Synthesis Repertory include Carcinosinum in rubrics associated with chronic respiratory conditions and constitutional hypersensitivity.
OBSERVATIONS
The data obtained from the 30 cases were analysed and presented as graphical presentation in forms of tables and charts.
TABLE : 1: AGE WISE DISTRIBUTION OF CASE
| Age groups No. of Patients Percentage (Years) (%) | ||
| 0-10 | 04 | 13.33% |
| 10-20 | 08 | 26.67% |
| 20-30 | 04 | 13.33% |
| 30-40 | 05 | 16.67% |
| 40-50 | 06 | 20% |
| 50-60 | 03 | 10% |
| Total | 30 | 100 |
Observation : Out of 30 cases, maximum cases belonged to the age group 10-20 years that is 08 (26.67%) cases, followed by 06 (20%) cases in 40-50 years age groups, 05(16.67%) cases in 30-40 years of age groups and 04 (13.33%) cases in 0-10 &20- 30years of age groups and 03(10%) cases in 50-60 years of age groups.
Figure 1 : Age wise Distribution of case

TABLE 2 : DISTRIBUTION ACCORDING TO DISEASE CONDITION
| Disease Condition No. of Patients Percentage (%) | ||
| Allergic Rhinitis | 10 | 33.33% |
| Chronic Sinusitis | 3 | 10% |
| Chronic Pharyngitis | 3 | 10% |
| Chronic Tonsilitis | 2 | 6.67% |
| Recurrent URTI | 1 | 3.33% |
| Acute Laryngitis | 3 | 10% |
| Recurrent Cold & Cough | 1 | 3.33% |
| Asthma | 3 | 10% |
| Chronic Bronchitis | 2 | 3.33% |
| Interstitial Lung Disease | 1 | 6.67% |
| Pneumonia | 1 | 3.33% |
| Total | 30 | 100% |
Observation : In the study, the disease condition classified into Allergic Rhinitis, Chronic Sinusitis, Chronic Pharyngitis, Chronic Tonsilitis, Recurrent URTI, Acute Laryngitis, Recurrent Cold & Cough, Asthma, Chronic Bronchitis, Interstitial Lung Disease, Pneumonia.
The maximum number of cases classified into Allergic Rhinitis 10(33.33%) cases.

Figure 2 : Disease Condition wise distribution of Cases
TABLE 3 : DISTRIBUTION OF ACCORDING TO UPPER REPIRATORY TRACT AND LOWER REPIRATORY TRACT ILLNESESS
| Comorbid Condition No. of Patients Percentage (%) | ||
| Upper Respiratory Tract Illnesses | 23 | 76.67% |
| Lower Respiratory Tract Illnesses | 7 | 23.33% |
| Total | 30 | 100% |
Observation : In the study, out of 30 cases 23 (76.77%) Patients having Upper Respiratory Tract Illnesses and 7(23.33%) Patients having Lower Respiratory Tract Illnesses.

Figure 3 : Distribution according to Upper Respiratory Tract & Lower Respiratory Tract case
TABLE 4 : DISTRIBUTION OF CASES AS PER FAMILY HISTORY
| Family history No. of Cases Percentage (%) | ||
| Cancer | 20 | 66.67% |
| Chronic respiratory condition | 28 | 93.33 % |
| Metabolic disorder | 15 | 50 % |
Out of 30 cases studied, 30 (100 %) showed a positive family history. The common conditions observed were cancer(66.67%), metabolic disorders(50%), and chronic respiratory complaints (93.33%)

Figure 4 : Showed a positive family history
RESULT
The total number of cases studied was 30. The cases were assessed on the basis of clinical improvement after homoeopathic treatment, and outcomes were categorized as follows :
TABLE 5 : DISTRIBUTION OF CASES AS PER RESULT
| Result | No. of Cases | Percentage (%) |
| Improvement | 19 | 63.33% |
| Moderate Improvement | 5 | 16.67% |
| Not Improvement | 6 | 20% |
| Total | 30 | 100% |
Out of 30 cases 19 (63.33%) were Improvement, 5 cases (16.67%) were Moderate Improvement, 6 Cases (20%) were Not Improvement.

Figure 5 : Result wise Distribution of Case
Discussion
The review of literature suggests that Carcinosinum has a significant role in the management of chronic respiratory illnesses, particularly in patients with allergic predisposition and strong family history of chronic diseases. Its deep constitutional action helps in modifying disease susceptibility rather than merely controlling symptoms. Proper case-taking and individualization are essential for the successful use of Carcinosinum.
Conclusion
The study showed that Carcinosinum is effective in improving symptoms of Upper Respiratory Tract Illnesses, when prescribed on the basis of individualized totality of symptoms.
Most patients reported a decrease in the severity of symptoms, improved energy levels, and better overall health. It also helped reduce the frequency of recurrence in chronic cases. Hence, Carcinosinum can play a valuable role in treating respiratory problems, especially in patients who match its constitutional indications.
Family history analysis highlighted cancer, metabolic disorders, and chronic respiratory complaints as major contributing factors in our study group.
References
1. Allen H.C. Keynotes and Characteristics with Comparisons.
2. Boericke W. Pocket Manual of Homoeopathic Materia Medica.
3. Clarke J.H. A Dictionary of Practical Materia Medica.
4. Kent J.T. Repertory of the Homoeopathic Materia Medica.
5. Burnett J.C. Diseases of the Liver.
Guided by : Dr. Manish Doctor

